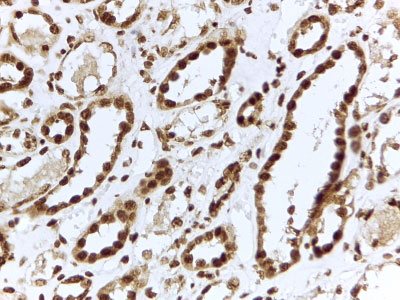

> Antigen, Antibodies, ELISA, Western Blot > Primary Antibody > Polyclonal Antibodies > ILF3 Antibody (internal region)Brand |
Leading Biology | Catalog Number |
APR16835G |
Product Type |
Polyclonal Antibodies | Field of Research |
|
Product Overview |
We constantly strive to ensure we provide our customers with the best antibodies. As a result of this work we offer this antibody in purified format.
We are in the process of updating our datasheets. If you have any questions regarding this update, please feel free to contact our technical support team.
This product is a high quality ILF3 antibody (internal region).
|
||
Molecular Weight |
95338 Da
|
||
Cellular Localization |
Antigen Cellular Localization:
Nucleus, nucleolus. Cytoplasm. Nucleus. Note=Localizes in the cytoplasm in response to viral dsRNA. The unphosphorylated form is retained in the nucleus by ILF2 Phosphorylation at Thr-188 and Thr-315 causes the dissociation of ILF2 from the ILF2-ILF3 complex resulting in a cytoplasmic sequestration of ILF3. Localized in cytoplasmic mRNP granules containing untranslated mRNAs
|
||
Host |
Goat
|
||
Species Reactivity |
Human
|
||
Isotype |
IgG
|
||
Symbol |
DRBF, MPHOSPH4, NF90
|
||
GeneID |
|||
UniProt ID |
|||
Function |
May facilitate double-stranded RNA-regulated gene expression at the level of post-transcription. Can act as a translation inhibitory protein which binds to coding sequences of acid beta-glucosidase (GCase) and other mRNAs and functions at the initiation phase of GCase mRNA translation, probably by inhibiting its binding to polysomes. Can regulate protein arginine N- methyltransferase 1 activity. May regulate transcription of the IL2 gene during T-cell activation. Can promote the formation of stable DNA-dependent protein kinase holoenzyme complexes on DNA. The phosphorylated form at Thr-188 and Thr-315, in concert with EIF2AK2/PKR can inhibit vesicular stomatitis virus (VSV) replication (By similarity).
|
||
Summary |
This antibody is expected to recognize isoforms a (NP_036350.2) and d (NP_060090.2).
|
||
Form |
0.5 mg/ml in Tris saline, 0.02% sodium azide, pH7.3 with 0.5% bovine serum albumin |
||
Storage & Stability |
Store at +4°C short term. For long-term storage, aliquot and store at -20°C or below. Stable for 12 months at -20°C. Avoid repeated freeze-thaw cycles.
|
||
Applications |
IHC, E
|
||
Synonyms |
Interleukin enhancer-binding factor 3, Double-stranded RNA-binding protein 76, DRBP76, M-phase phosphoprotein 4, MPP4, Nuclear factor associated with dsRNA, NFAR, Nuclear factor of activated T-cells 90 kDa, NF-AT-90, Translational control protein 80, TCP80, ILF3, DRBF, MPHOSPH4, NF90
|
||
Images |
APR16835G (2 μg/ml) staining of paraffin embedded Human Kidney. Steamed antigen retrieval with citrate buffer pH 6, HRP-staining. |
||
Specification |
|||
Quantity |
|
||
| Select | Brand | Catalog No. | Product Name | Pack Size | Type | Field of Research | Specification | Quantity | Price(USD) | |
| 1 | Leading Biology | APR03440G | ITGA11 Antibody (N-term) | 100 μl | Polyclonal Antibodies |
|
$495.00 | Add Ask | ||
| 2 | Leading Biology | APR04537G | CMIP Antibody (C-term) | 100 μl | Polyclonal Antibodies |
|
$495.00 | Add Ask | ||
| 3 | Leading Biology | APR12422G | Human H4 Histamine Receptor (extracellular) Antibody | 50 μl | Polyclonal Antibodies |
|
$695.00 | Add Ask | ||
| 4 | Leading Biology | APR03844G | UBE2W Antibody (C-term) | 100 μl | Polyclonal Antibodies |
|
$495.00 | Add Ask | ||
| 5 | Leading Biology | APR04349G | HECTD2 Antibody (N-term) | 100 μl | Polyclonal Antibodies |
|
$495.00 | Add Ask | ||
| 6 | Leading Biology | APR03502G | IGHG1 Antibody (Center) | 100 μl | Polyclonal Antibodies |
|
$495.00 | Add Ask |
 Leading Biology Inc.
2600 Hilltop DR, Building G, B Suite C138
Richmond, CA, 94806
Tel: 1-661-524(LBI)-0262
Email: info@leadingbiology.com
Leading Biology Inc.
2600 Hilltop DR, Building G, B Suite C138
Richmond, CA, 94806
Tel: 1-661-524(LBI)-0262
Email: info@leadingbiology.com
Complete this form and click send to ask us a question, request a quote or simply say hello.

You have 0 item in your cart

You have 0 item in your inquiry list
